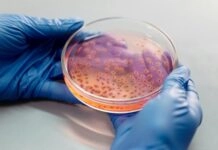

Ξεκινάει ο εμβολιασμός κατά της εποχικής γρίπης
Κάλεσμα στους πολίτες να εμβολιαστούν έγκαιρα, να τηρούν τις οδηγίες προστασίας και να συμβάλλουν στην πρόληψη σοβαρών επιπλοκών και στη μείωση των νοσηλειών...
Έρευνα: Ο κακός ύπνος γερνάει πρόωρα τον εγκέφαλο αυξάνοντας τον κίνδυνο νευρολογικών διαταραχών
Ζωτική σημασία φαίνεται να έχει ο επαρκής και ποιοτικός ύπνος στην κατάσταση του ανθρώπινου εγκεφάλου και στη φυσιολογική φθορά του. Πρόσφαστη μελέτη στο...
Η πλανητική διατροφή ως απάντηση στην κλιματική κρίση – Μπορεί να προλάβει 15 εκατ....
Δεκαπέντε εκατομμύρια πρόωροι θάνατοι ετησίως μπορούν να αποφευχθούν αν υιοθετηθεί σε παγκόσμιο επίπεδο η λεγόμενη πλανητική διατροφή (Planetary Health Diet – PHD), αναφέρει...
Προειδοποίηση ΠΟΥ για τα ανθεκτικά μικρόβια καθώς η φαρέτρα των αντιβιοτικών εξαντλείται
Η ανθρωπότητα χάνει στον αγώνα δρόμου απέναντι στα ανθεκτικά μικρόβια, προειδοποιεί με νέες εκθέσεις του ο Παγκόσμιος Οργανισμός Υγείας, καθώς ελάχιστα νέα αντιβιοτικά...
Χάσαμε σχεδόν 3,5 χρόνια υγιούς γήρανσης την τελευταία 10ετία
Τριπλάσια είναι πλέον τα άτομα ηλικίας άνω των 65 ετών, καθώς από 280 εκατομμύρια το 1980 αυξήθηκαν σε 761 εκατομμύρια το 2021.Μέχρι το...
Κορονοϊός: Διπλάσιος ο κίνδυνος long covid στα παιδιά έπειτα από δεύτερη μόλυνση
Τα παιδιά και οι έφηβοι έχουν διπλάσιες πιθανότητες να εμφανίσουν long Covid έπειτα από δεύτερη μόλυνση, σε σύγκριση με όσους έχουν μολυνθεί μία...
Χάνεται το 20% των δαπανών υγείας σε άχρηστες ή κακές ιατρικές παρεμβάσεις
Υπηρεσίες υγείας άχρηστες ή χαμηλής ποιότητας πληρώνουμε, καταβάλλοντας το 20% των δαπανών υγείας συνολικά, με αποτέλεσμα να χάνονται πάνω από 2 δις στην...
Το πρόχειρο φαγητό ίσως πλήττει τη μνήμη μέσα σε μόλις 4 ημέρες
Τέσσερις ημέρες πρόχειρου φαγητού είναι αρκετές ώστε να πληγεί το κέντρο της μνήμης του εγκεφάλου! Αυτό προέκυψε από μια νέα μελέτη ερευνητών της...
Ηλίας Μόσιαλος: Στον αλγόριθμο το κλειδί για αξιοπιστία της τεχνητής νοημοσύνης στην υγεία
«Οι κατευθυντήριες οδηγίες έχουν θεσπιστεί για να μας προστατεύουν από μέτριους επαγγελματίες υγείας. Οι έμπειροι και καλοί γιατροί υπάρχουν, για να μας προστατεύουν...
Πληρωμή των νοσοκομείων με ποιοτικά κριτήρια ετοιμάζει ο ΕΟΠΥΥ
Ποιοτικά κριτήρια αποζημίωσης ζητά ο ΕΟΠΥΥ να καθιερωθούν και στα δημόσια νοσοκομεία μετά την εφαρμογή του νέου συστήματος κοστολόγησης των υπηρεσιών που παρέχουν...